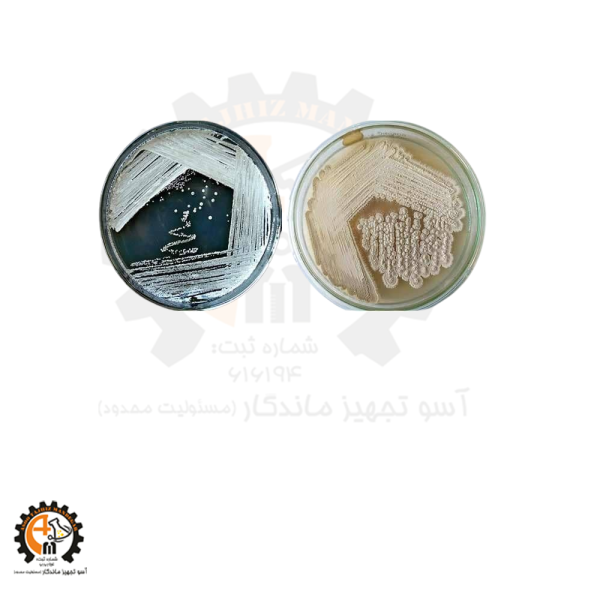
محیط کشت استارچ کازئن آگار Starch Casein Agar یا SCA
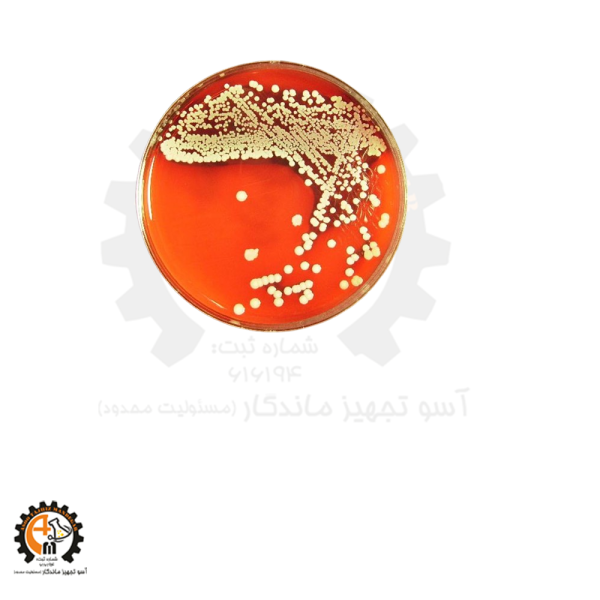
محیط کشت استوارت ترانسپورت stuart transport medium
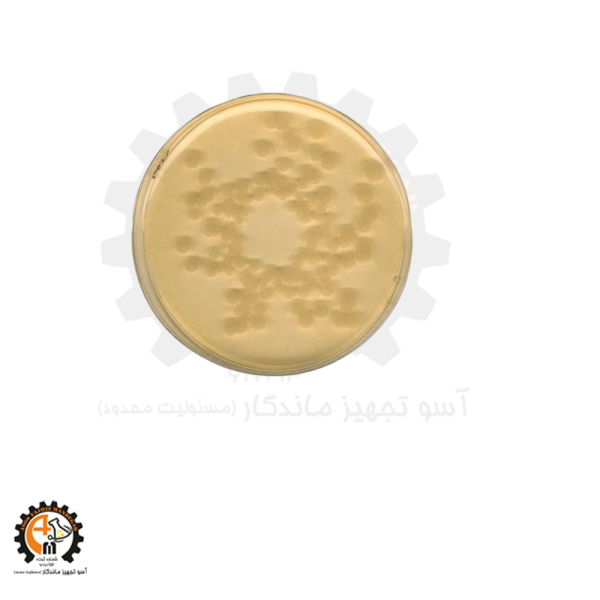
محیط کشت باسیلوس سرئوس کیولب MYP Culture Medium
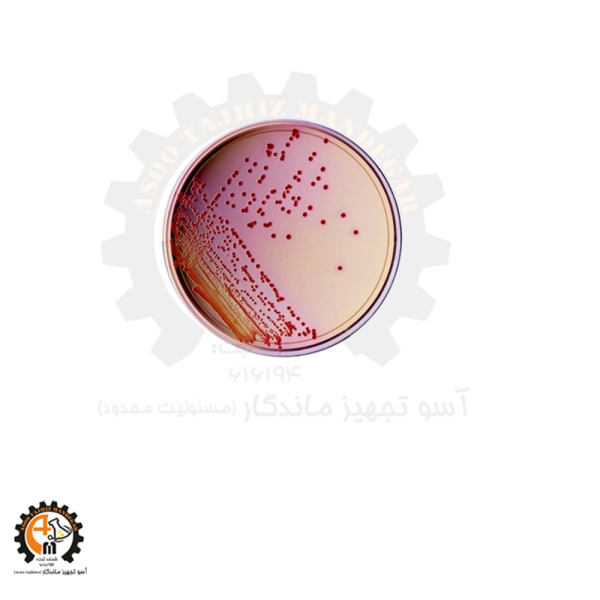
محیط کشت جیولیتی کانتونی براث Giolitti-Cantoni Broth

محیط کشت ها
در حال نمایش 54 نتیجه
-

Opti-MEM 100ml برند Gibco | محیط کشت کاهشیافته سرم برای کشت سلولی تخصصی
اطلاعات بیشتر -

TSB محیط کشت تریپتیک سوی براث 105459 (Tryptic Soy Broth)
اطلاعات بیشتر -

باسیلوس سرئوس سلکتیو ساپلمنت کد 109875 مرک
اطلاعات بیشتر -

تورین (Thorin) کد 108294 اصلی مرک
اطلاعات بیشتر -

تیوگل کولات براث ۱۰۷۶۶۱ (Thioglycollate Broth)
اطلاعات بیشتر -

خرید بنزیل آدنین مرک 101701
اطلاعات بیشتر -

خرید پودر محیط کشت RPMI 1640 برند Gibco | کیفیت برتر برای کشت سلولی حرفهای
اطلاعات بیشتر -

خرید محیط کشت TSC مرک 111972
اطلاعات بیشتر -

خرید و قیمت 1-آمینو هیدروکسی-4-نفتالن سولفونیک اسید کد 100099 اصلی مرک
اطلاعات بیشتر -

خرید و قیمت 1-اتیل-3-متیل ایمیدازولیوم تترافلوروبورات (EMIM BF4) – کد 711721
اطلاعات بیشتر -

خرید و قیمت باریم تیتانات(IV) (Barium Titanate) کد 338842 اصلی سیگما – کاربردها، مشخصات و قیمت
اطلاعات بیشتر -

خرید و قیمت پتاسیم استات (Potassium Acetate) کد 104820 اصلی مرک
اطلاعات بیشتر -

خرید و قیمت تریپتون واتر مرک Merck 110859
اطلاعات بیشتر -

خرید و قیمت محیط کشت Lactose TTC Agar with Tergitol-7 کد 107680 اصلی مرک
اطلاعات بیشتر -

خرید و قیمت محیط کشت Plate Count Skim Milk Agar (PCMA) – کد 115338 اصلی مرک
اطلاعات بیشتر -

خرید و قیمت محیط کشت RBC مرک 100467 | Rose Bengal Agar
اطلاعات بیشتر -

خرید و قیمت محیط کشت TAA
اطلاعات بیشتر -

خرید و قیمت محیط کشت برلیانت گرین براث (Brilliant Green Bile Broth) مرک 105454
اطلاعات بیشتر -

خرید و قیمت محیط کشت پپتون پروتئوز مرک (Merck 107229)
اطلاعات بیشتر -

خرید و قیمت محیط کشت پپتون سویا مرک (Merck 107212)
اطلاعات بیشتر -

خرید و قیمت محیط کشت تریپل شوگر آیرون آگار (TSI)
اطلاعات بیشتر -

خرید و قیمت محیط کشت تیوگلیکولات براث کد 108720 اصلی مرک
اطلاعات بیشتر -

خرید و قیمت محیط کشت جیولیتی کانتونی براث مرک
اطلاعات بیشتر -

خرید و قیمت محیط کشت سابرود دکستروز آگار (SDA)
اطلاعات بیشتر -

خرید و قیمت محیط کشت سودوموناس آگار F مرک (Merck 110989)
اطلاعات بیشتر -

خرید و قیمت محیط کشت سودوموناس سلکتیو آگار کد 107620 اصلی مرک
اطلاعات بیشتر -

خرید و قیمت محیط کشت شکلات آگار (Chocolate Agar) مرک کد 146093
اطلاعات بیشتر -

خرید و قیمت محیط کشت فلوئید تیوگلیکولات مدیوم کد 146314 اصلی مرک
اطلاعات بیشتر -

سزیم یدید(Cesium iodide) کد 202134
اطلاعات بیشتر -

محیط کشت (MR-VP broth) کد 105712
اطلاعات بیشتر -

محیط کشت prime DG 18 واحد 500 گرم کد 100465 مرک آلمان
اطلاعات بیشتر -

محیط کشت RPMI 1640 100ml گیبکو | محیط استاندارد برای رشد سلولهای یوکاریوتی
اطلاعات بیشتر -

محیط کشت TSI آگار لیوفیلکم
اطلاعات بیشتر -

محیط کشت استارچ کازئن آگار Starch Casein Agar یا SCA
اطلاعات بیشتر -

محیط کشت استوارت ترانسپورت stuart transport medium
اطلاعات بیشتر -

محیط کشت امولسیون زرده تخم مرغ تلوریت دار103785 Egg Yolk Tellurite Emulsion
اطلاعات بیشتر -

محیط کشت باسیلوس سرئوس کیولب MYP Culture Medium
اطلاعات بیشتر -

محیط کشت بلاد آگار مرک ۱۱۰۸۸۶ (Blood Agar)
اطلاعات بیشتر -

محیط کشت پلیت کانت آگار کد 105463
اطلاعات بیشتر -

محیط کشت تریپتیک سوی آگار TSA
اطلاعات بیشتر -

محیط کشت تقویت شده کلستریدیال GranuCult® Prime RCM105411
اطلاعات بیشتر -

محیط کشت جیولیتی کانتونی براث Giolitti-Cantoni Broth
اطلاعات بیشتر -

محیط کشت خون مایع حاوی SPS کودکان
اطلاعات بیشتر -

محیط کشت ردی کلران رزبنگال کلرامفنیکول (DRBC) مرک 100466
اطلاعات بیشتر -

محیط کشت سالمونلا شیگلا کیولب SS AGAR
اطلاعات بیشتر -

محیط کشت سولفیت آیرون آگار ۱۱۰۸۶۴ (Sulfite Iron Agar)
اطلاعات بیشتر -

محیط کشت سیمون سیترات آگار GranuCult® prime SIMMONS Citrate Agar کد مرک 103855
اطلاعات بیشتر -

محیط کشت سیمون سیترات آگار Simmons Citrate Agar
اطلاعات بیشتر -

محیط کشت لوریل سولفات براث 110266 (Lauryl Sulfate Broth)
اطلاعات بیشتر -

محیط کشت مک کانکی آگار کیولب MACONKEY AGAR MAC
اطلاعات بیشتر -

محیط کشت مولر هینتون آگار 105437 (MUELLER-HINTON Agar)
اطلاعات بیشتر -

محیط کشت میدل بروک آگار بیس 7H10 کد M0303
اطلاعات بیشتر -

محیط کشت ویولت رد بایل آگار VRBA
اطلاعات بیشتر -

محیط کشت ویولت رد بایل لاکتوز آگارکیولب VRBL (Violet Red Bile Lactose) agar
اطلاعات بیشتر
"" به سبد خرید شما اضافه شد.نمایش سبد